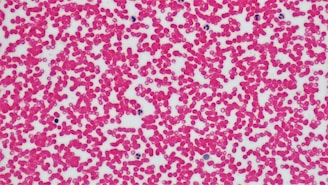

বিশেষজ্ঞ রক্ত চিকিৎসক
ডা. আরিফ উর রহমানের আধুনিক এবং বিশ্বমানের সেবা গ্রহণ করুন।
হেমাটোলজিস্ট আরিফ উর রহমানের সেবাসমূহ
রক্তরোগের সঠিক নির্ণয় ও উন্নত চিকিৎসা সেবায় ডা. আরিফ উর রহমান প্রতিশ্রুতিবদ্ধ প্রতিটি রোগীর সুস্থতা ও নিরাপত্তায়।
রক্তরোগ নির্ণয়
অ্যানিমিয়া, থ্যালাসেমিয়া, ব্লাড ক্যান্সার, প্লেটলেট সমস্যা এবং রক্ত জমাট বাঁধার জটিলতা নির্ণয় ও চিকিৎসা।


থ্যালাসেমিয়া কেয়ার
নিয়মিত ব্লাড ট্রান্সফিউশন, আয়রন মনিটরিং, ও থ্যালাসেমিয়া রোগীদের সার্বিক চিকিৎসা ব্যবস্থাপনা।
লিউকেমিয়া, লিম্ফোমা ও মাইলোমা রোগীদের জন্য আধুনিক কেমোথেরাপি, ডায়াগনস্টিক ও সাপোর্টিভ কেয়ার।
ব্লাড ক্যান্সার চিকিৎসা

প্লেটলেট ও ক্লটিং ডিসঅর্ডার কেয়ার
DVT, ITP, কোয়াগুলেশন ডিজঅর্ডারসহ বিভিন্ন জটিল রক্তক্ষরণজনিত রোগের চিকিৎসা।


অ্যানিমিয়া ও রক্তশূন্যতার চিকিৎসা
সঠিক রোগ নির্ণয়, পুষ্টি ব্যবস্থাপনা ও প্রয়োজন অনুযায়ী আধুনিক চিকিৎসা সেবা।
রোগ প্রতিরোধ, সচেতনতা ও চিকিৎসা–সংক্রান্ত শিক্ষামূলক কনটেন্টের মাধ্যমে সঠিক তথ্য প্রচার।
রোগী সচেতনতা ও হেলথ এডুকেশন




রোগীদের গল্প
রোগীদের নিজের মুখে তাদের গল্প শুনুন


যোগাযোগ করুন
আমাদের সেবাসমূহের বিষয়ে জানতে বা appointment নিতে, দয়া করে যোগাযোগ করুন। আমরা আপনাকে সাহায্য করতে প্রস্তুত।
ফোন
+88011717672805
ইমেইল
hello@hematologistarif.com
ডাক্তারের চেম্বারসমূহ
ডা. আরিফ উর রহমানের ক্লিনিক রক্তরোগ ও ব্লাড ক্যান্সারের জন্য বিশেষজ্ঞ সেবা প্রদান করেন। তিনি ঢাকা মেডিকেলের বাইরেও আরো তিনটি হসপিটাল এবং ক্লিনিকে সেবা প্রদান করেন।
ঠিকানা
ইনসাফ বারাকাহ কিডনি এন্ড জেনারেল হাসপাতাল 📍 , ঢাকা
ইবনে সিনা, সাভার শাখা 📍 সাভার
পপুলার ডায়াগনস্টিক সেন্টার 📍 মাইজদী, নোয়াখালী
কখন বসেন
সপ্তাহে ৬ দিন সন্ধ্যা ৭টা থেকে রাত ১০টা
সহযোগী অধ্যাপক (হেমাটোলজি)
ঢাকা মেডিকেল কলেজ ও হাসপাতাল
Contact
Copyright @ 2025 Dr Arif Ur Rahman | Developed by The YOLO Lab


Stay Connected
জয়েন করুন
